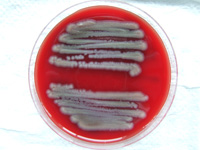

Detecting Dangerous Bacteria without Loss of Time
Brussels, 27.09.2010. Bacteria are everywhere - in the air, on our food and skin. In the air of operating rooms or in food processing however, the presence of a single bacterial cell can be dangerous. To avoid damage or high costs it is crucial to identify these pathogens quickly, but conventional detection methods currently need up to three days for identification. Scientists from the EU-network Photonics4Life have now developed a rapid on-site monitor, which can accurately characterize a single bacterium within a second.
(firmenpresse) - Right now the device is capable of detecting bacteria in the air and hence is perfectly suited for the use in clean rooms for pharmaceutical production. In the next step the researches will adapt their system for the use in clinics, as every year about 40,000 patients die from Sepsis in Germany alone. Also up to three of 100 patients get infected during their hospital stay in the western world. “To apply the most effective antibiotic the physician quickly needs to know which type of bacteria caused the infection of the patient”, says Prof. Jürgen Popp, coordinator of the network Photonics4Life.
The basis for the real-time monitoring his network offers is Raman spectroscopy. It detects and identifies bacteria without a precultivation and in contrast to existing methods like microbiology or genetic testing is sensitive enough to detect single microbes. This is because the back-scattered laser light of the probe, called the Raman spectrum, inherits information about its biomolecular components. These can be interpreted as an optical fingerprint of this very bacterial species. An implemented database of Raman spectra allows the identification of the particle through its spectrum.
In cooperation with doctors and other companies the scientists from the network will build up this database over the next years containing the characteristics of hospital bacteria. “We also plan to integrate molecular biological analysis to determine both the possible resistance of bacteria to antibiotics and the body's response to the pathogens closely”, explains Prof. Michael Bauer from the University Hospital Jena. The anesthesiologist is one of the doctors involved in the project. Once finished, the system could be used in routine health monitoring and substantially fasten the detection of life-threatening bacteria and even fungi and yeasts in blood and other body fluids.
Photonics4Life (P4L) is the European Network of Excellence for Biophotonics, a discipline where optical technologies are used to detect diseases earlier, to understand their causes and to provide targeted treatments. In the network top-of-the-line research institutes have joined forces to establish a European platform on Biophotonics for both academia and industry. Their major goal is to initiate a paradigm shift in research by putting the emphasis on the needs of biologists, physicians and patients and to strengthen local, national, and European research and communication activities between technical developers and medical users. Photonics4Life is funded by the European Commission within the 7th Framework Programme. More information about the network can be found under http://www.photonics4life.eu.
Other involved companies and research institutes:
•R-Biopharm AG, Darmstadt
•rap.ID GmbH, Berlin
•QIAGEN GmbH, Hilden
•University Hospital Dresden
Public Presentation
The on-site monitor for the detection of bacteria in air will be on display under the name Bioparticle Explorer on the Information Technology Fair ICT at the Brussels Expo from September 27 to 29. There involved scientists will also explain the manifold advantages for its adapted use in clinics.
Unternehmensinformation / Kurzprofil:
Photonics4Life is the European Network of Excellence for Biophotonics. More than 20 top-of-the-line research institutes, all active in the broad domain of Biophotonics, have joined forces to establish a European platform on Biophotonics for both academia and industry. Our aim is to provide a coherent and interdisciplinary framework for research in the strongly fragmented field of Biophotonics in Europe.
Prof. Jürgen Popp
Coordinator
Phone +49 (0) 3641 · 206-300
Telefax +49 (0) 3641 · 206-399
juergen.popp(at)ipht-jena.de
Institute of Photonic Technology
Albert-Einstein-Str. 9
D-07745 Jena
Clemens Homann
Public Relations
Phone +49 (0) 3641 · 206-064
Telefax +49 (0) 3641 · 206-044
Clemens.homann(at)ipht-jena.de
Institute of Photonic Technology
Albert-Einstein-Str. 9
D-07745 Jena
Datum: 26.09.2010 - 19:05 Uhr
Sprache: Deutsch
News-ID 25442
Anzahl Zeichen: 0
contact information:
Contact person: Clemens Homann
Town:
Jena
Phone: +493641206064
Kategorie:
Healthcare & Medical
Typ of Press Release: Erfolgsprojekt
type of sending: Veröffentlichung
Date of sending: 27.09.2010
Diese Pressemitteilung wurde bisher 403 mal aufgerufen.
Die Pressemitteilung mit dem Titel:
"Detecting Dangerous Bacteria without Loss of Time"
steht unter der journalistisch-redaktionellen Verantwortung von
Photonics4Life (Nachricht senden)
Beachten Sie bitte die weiteren Informationen zum Haftungsauschluß (gemäß TMG - TeleMedianGesetz) und dem Datenschutz (gemäß der DSGVO).